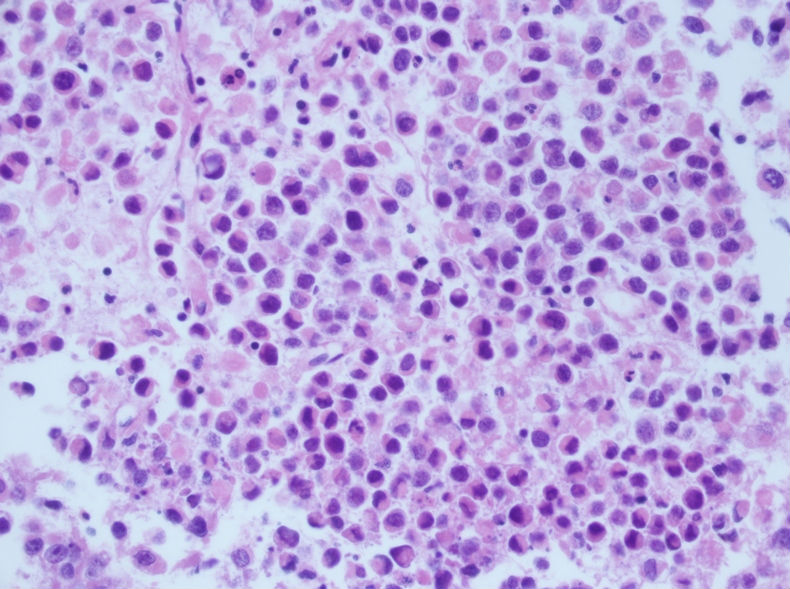

| 图片: | |
|---|---|
| 名称: | |
| 描述: | |
- 男性,30岁,左腹股沟淋巴结穿刺
名称:图1
描述:F20107050400 6.jpg.jpg
描述:F20107050400 6.jpg.jpg

名称:图2
描述:F20107050200 3.jpg.jpg

名称:图3
描述:F20107050400 1.jpg.jpg

名称:图4
描述:F20107050200 1.jpg.jpg

名称:图5
描述:F20107050200 2.jpg.jpg

名称:图6
描述:F20107050200 4.jpg.jpg

名称:图7
描述:F20107050400 5.jpg.jpg

名称:图8
描述:F20107050100 1.jpg.jpg

名称:图9
描述:F20107050400 3.jpg.jpg

名称:图10
描述:F20107050100 2.jpg.jpg

名称:图11
描述:F20107050400 2.jpg.jpg

名称:图12
描述:F20107050400 4.jpg.jpg

名称:图13
描述:F2010705050 1.jpg.jpg
标签:
×参考诊断
淋巴结转移性精原细胞瘤
-
liguoxia71 离线
- 帖子:4174
- 粉蓝豆:3122
- 经验:4677
- 注册时间:2007-04-01
- 加关注 | 发消息